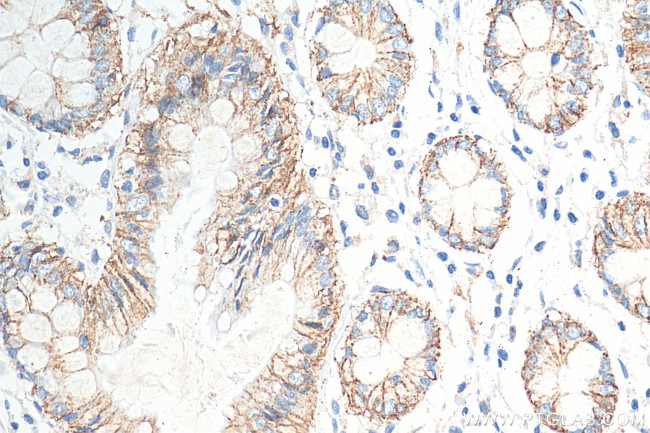
Claudin 7 Antibody in Immunohistochemistry (Paraffin) (IHC (P))

Search
Proteintech
Claudin 7 Polyclonal Antibody
{{$productOrderCtrl.translations['antibody.pdp.commerceCard.promotion.promotions']}}
{{$productOrderCtrl.translations['antibody.pdp.commerceCard.promotion.viewpromo']}}
{{$productOrderCtrl.translations['antibody.pdp.commerceCard.promotion.promocode']}}: {{promo.promoCode}} {{promo.promoTitle}} {{promo.promoDescription}}. {{$productOrderCtrl.translations['antibody.pdp.commerceCard.promotion.learnmore']}}
产品信息
29795-1-AP
种属反应
宿主/亚型
分类
类型
抗原
偶联物
形式
纯化类型
保存液
内含物
保存条件
运输条件
产品详细信息
Immunogen sequence: NPLIPTNIKY EFGPAIFIGW AGSALVILGG ALLSCSCPGN ESKAGYRAPR SYPKSNSSKE YV
靶标信息
This gene encodes a member of the claudin family. Claudins are integral membrane proteins and components of tight junction strands. Tight junction strands serve as a physical barrier to prevent solutes and water from passing freely through the paracellular space between epithelial or endothelial cell sheets, and also play critical roles in maintaining cell polarity and signal transductions. Differential expression of this gene has been observed in different types of malignancies, including breast cancer, ovarian cancer, hepatocellular carcinomas, urinary tumors, prostate cancer, lung cancer, head and neck cancers, thyroid carcinomas, etc. Alternatively spliced transcript variants encoding different isoforms have been found.
仅用于科研。不用于诊断过程。未经明确授权不得转售。
篇参考文献 (0)
生物信息学
蛋白别名: Claudin-7; CLDN-7; clostridium perfringens enterotoxin receptor-like 2; epididymis secretory sperm binding protein; unnamed protein product
基因别名: CEPTRL2; claudin-1; CLDN-7; CLDN7; CPETRL2; Hs.84359
UniProt ID: (Human) O95471, (Mouse) Q9Z261
Entrez Gene ID: (Human) 1366, (Mouse) 53624